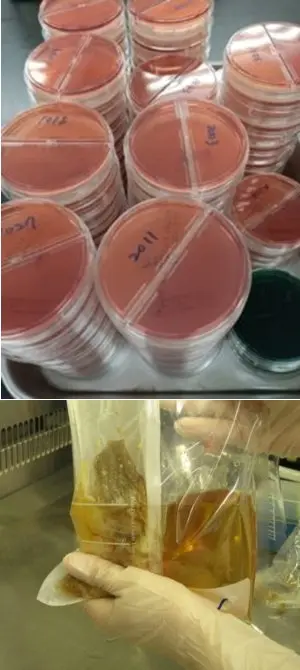

- HOME
- 診療科のご案内
- 中央診療部門、管理運営部門など
- 臨床検査部
- 部門紹介
- 細菌検査
臨床検査部
細菌検査
概要
細菌検査室では、感染症の原因となっている細菌や真菌(かび)などを調べる検査を行っています。また、他の部門と連携した活動も精力的に行っています(ICT活動、環境検査、水の培養検査など)。
一般細菌検査 - 顕微鏡検査

患者さんから採取された検体は細菌検査室に提出されます。受付された検体をスライドガラスに塗布し、グラム染色を行い顕微鏡で観察します。グラム染色の色調や菌の形状で、検体の中に潜んでいる菌の種類を推定します。
一般細菌検査 - 培養・同定検査

患者さんから採取された検体(喀痰、尿、便、血液、膿など)を培養することで、感染症の原因菌を調べる検査です。菌が発育するために必要な栄養を含む寒天培地に検体を接種し、培養を行います。培地に塊(コロニー)となって発育してくる菌を調べ、菌の種類を決定します。
一般細菌検査 - 薬剤感受性検査

感染症の原因菌に対して有効な薬剤を調べる検査です。抗菌薬の選択や院内感染対策に貢献しています。
抗酸菌検査

抗酸菌(結核菌など)の検査です。他の菌と違って、抗酸菌は発育に大変時間がかかります。顕微鏡検査や遺伝子検査も使って、迅速に結果を担当医に届けています。
ウイルス検査・遺伝子検査

インフルエンザウイルスやロタウイルスなどの迅速抗原検査の他にも、B型・C型肝炎ウイルスの遺伝子検査(リアルタイムPCR)を実施しています。 また、新型コロナウイルスの解析のため、全ゲノム配列を調べることができる次世代シーケンサが導入されました。今後のさまざまな活用が期待されます。
感染制御チーム(Infection Control Team, ICT)活動

感染制御チーム(ICT)は、医師・看護師・薬剤師・臨床検査技師など多職種のスタッフで構成される院内の感染対策を行う組織です。細菌検査室では、検査で得られた情報をICTへ還元し、院内感染対策に貢献しています。また、様々な病院内活動にも関わっています。
栄養部と連携した検査
厨房の環境検査や栄養部職員の定期的な検査(腸内細菌検査、ノロウイルス検査など)を実施しています。
病院施設課と連携した活動

院内冷却塔水の定期的な環境検査(レジオネラ検査)などを実施しています。